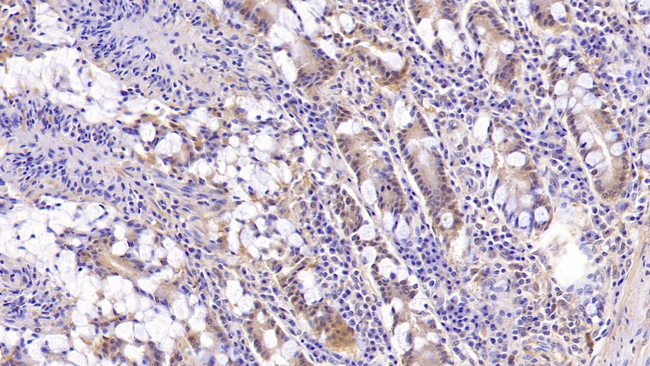
MUC5B Antibody in Immunohistochemistry (Paraffin) (IHC (P))

Search
Invitrogen
MUC5B Monoclonal Antibody (C8)
{{$productOrderCtrl.translations['antibody.pdp.commerceCard.promotion.promotions']}}
{{$productOrderCtrl.translations['antibody.pdp.commerceCard.promotion.viewpromo']}}
{{$productOrderCtrl.translations['antibody.pdp.commerceCard.promotion.promocode']}}: {{promo.promoCode}} {{promo.promoTitle}} {{promo.promoDescription}}. {{$productOrderCtrl.translations['antibody.pdp.commerceCard.promotion.learnmore']}}
图: 1 / 1
MUC5B Antibody (MA566090) in IHC (P)

Please note: We are reviewing Western blot images included in the antibody testing data in our catalog, including those provided by third parties. Unless expressly labeled or annotated as “raw-unedited”, Western blot images included in the antibody testing data in our catalog may have been edited, optimized or otherwise adjusted for presentation.
产品信息
MA566090
种属反应
宿主/亚型
分类
类型
克隆号
抗原
偶联物
形式
浓度
规格
纯化类型
保存液
内含物
保存条件
运输条件
RRID
靶标信息
Mucins (MUCs) are heavily glycosylated glycoproteins that are synthesized either as membrane-bound or secreted proteins. Mucins are noteworthy because they have an aberrant expression profile in various malignancies. Mucins normally play a protective role for epithelial tissues and are expressed in the gastrointestinal, respiratory, and genito-urinary tracts. Mucins may also be involved in the renewal and differentiation of the epithelium, and the modulation of cell adhesion and cell signaling. MUC5B is thought to play a vital role in maintaining oral health, and may also be involved in respiratory and oral disease.2 MUC5B expression has been studied in gastric carcinoma as well as chronic obstructive pulmonary disease.
仅用于科研。不用于诊断过程。未经明确授权不得转售。
篇参考文献 (0)
生物信息学
蛋白别名: Cervical mucin; High molecular weight salivary mucin MG1; MUC-5B; Mucin-5 subtype B, tracheobronchial; Mucin-5B; Sublingual gland mucin
基因别名: MUC5; MUC5B
Entrez Gene ID: (Pig) 110259164